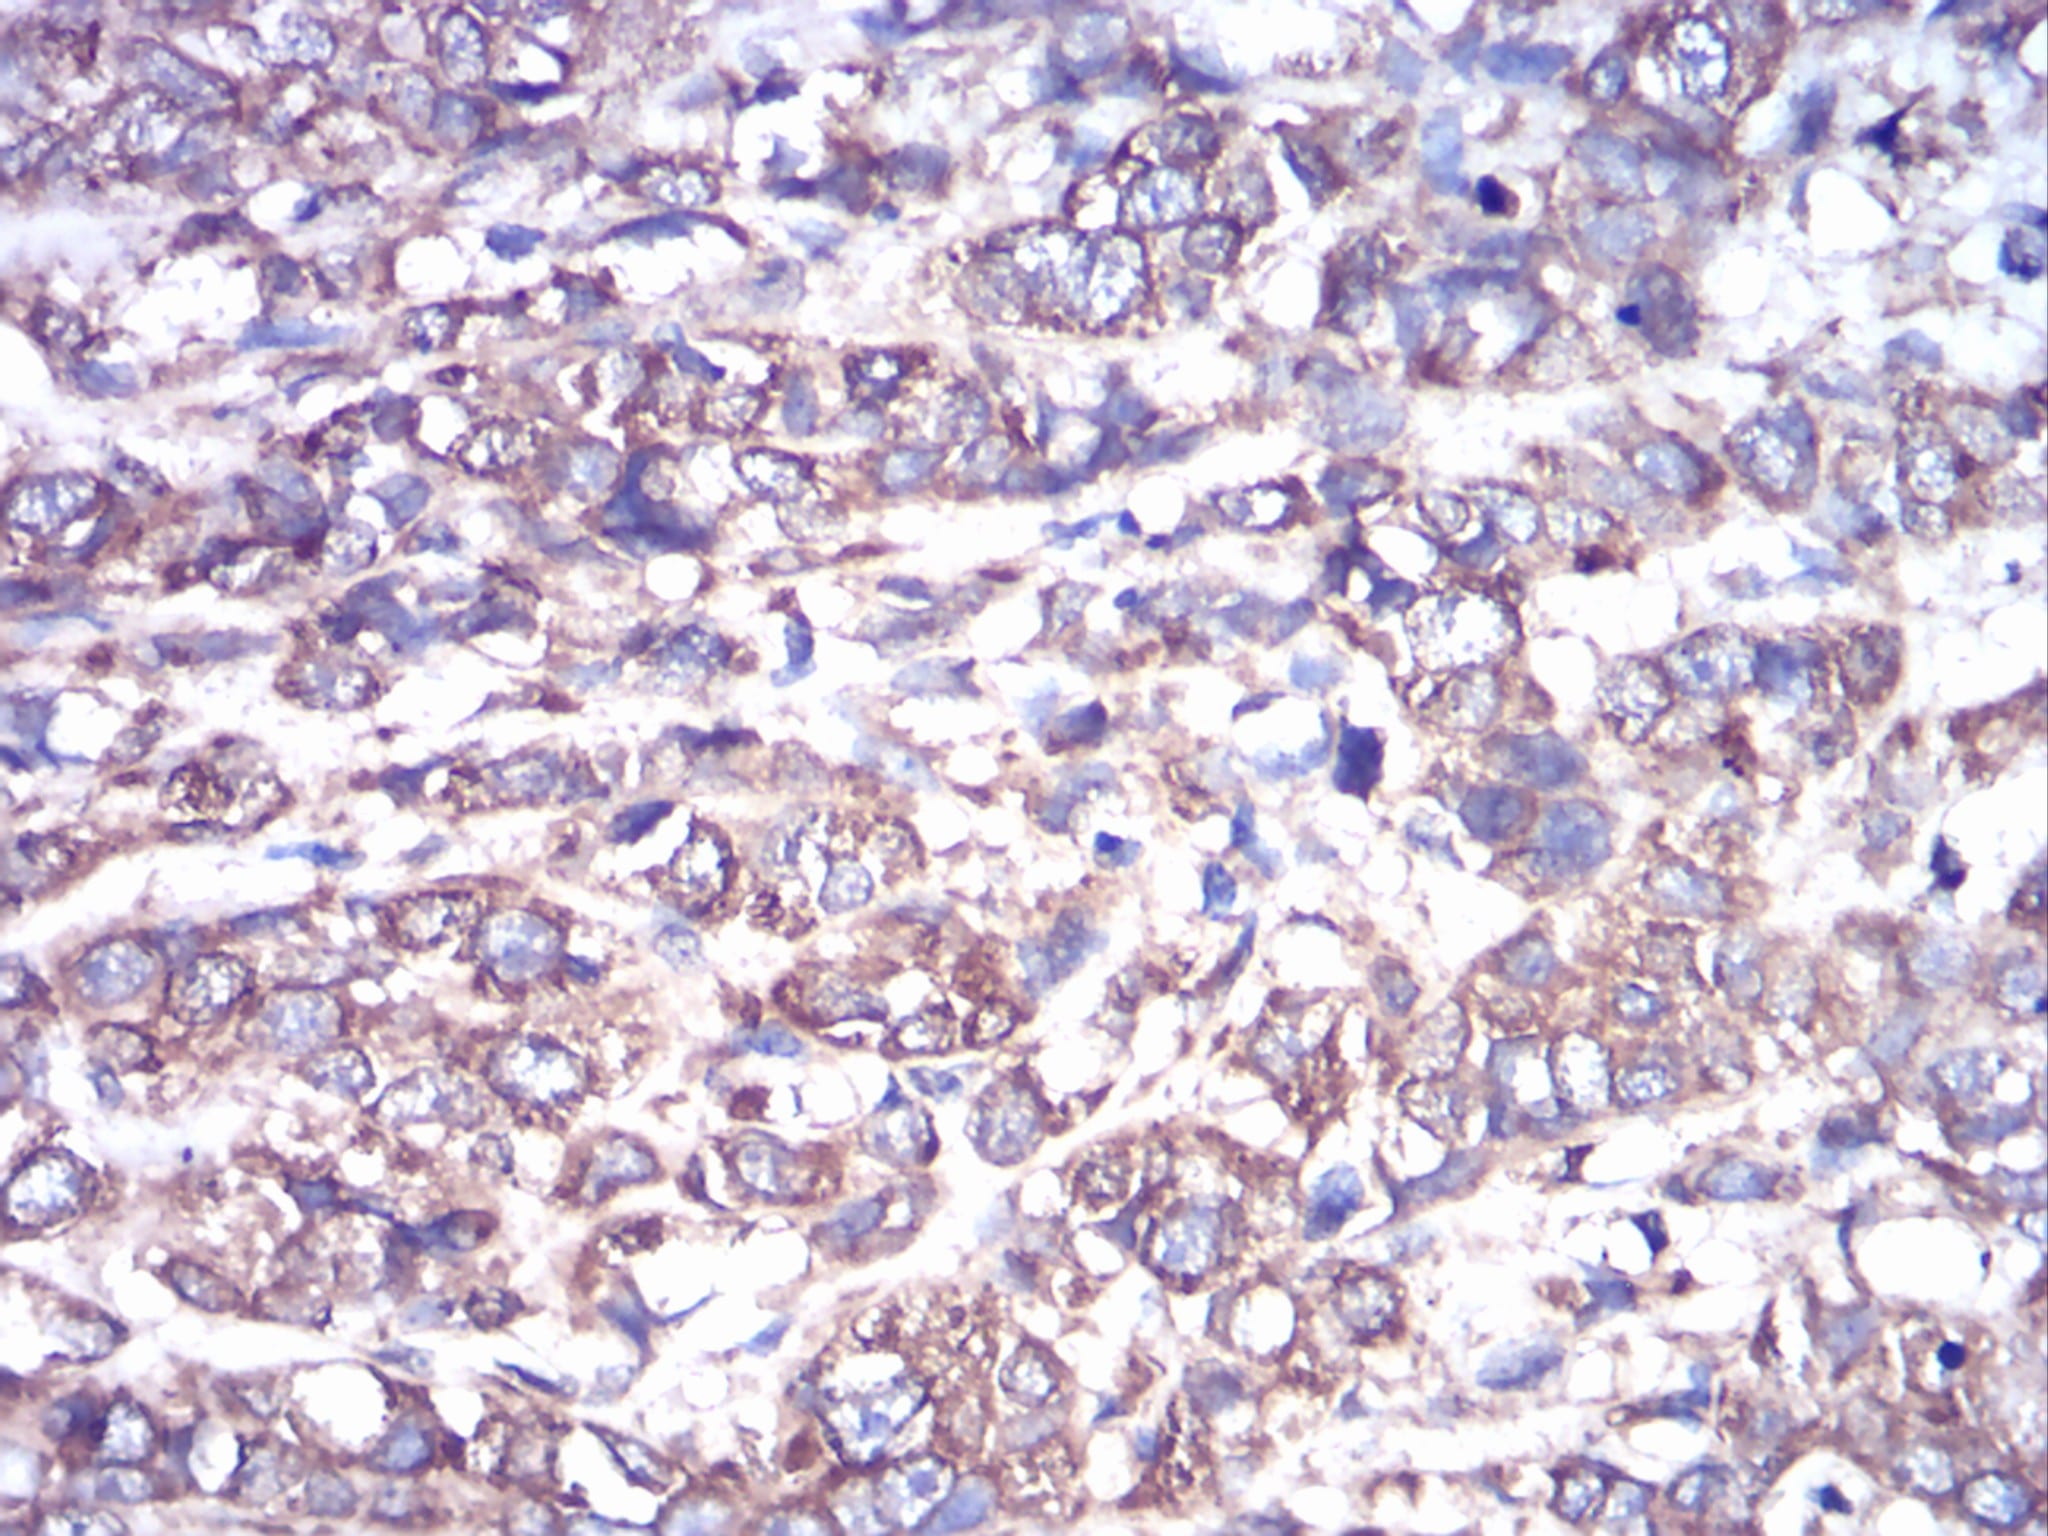

-
分类: 科研抗体货号: 30814别名: BDA2; BMP2A应用: IF,FCM反应种属: Human
-
分类: 科研抗体货号: 30798别名: IKBA; MAD-3; NFKBI应用: IF,FCM反应种属: Human
-
分类: 科研抗体货号: 30782别名: UV20; COFS4; RAD10应用: IF,FCM反应种属: Human
-
分类: 科研抗体货号: 30813别名: BDA2; BMP2A应用: FCM反应种属: Human
-
分类: 科研抗体货号: 30797别名: IKBA; MAD-3; NFKBI应用: IHC,IF,FCM反应种属: Human
-
分类: 科研抗体货号: 30781别名: AHO; GSA; GSP; POH; GPSA; NESP; GNAS1; PHP1A; PHP1B; PHP1C; C20orf45应用: IHC,FCM反应种属: Human
-
分类: 科研抗体货号: 30812别名: KOX; KOX-1; RENOX应用: IHC,IF,FCM反应种属: Human
-
分类: 科研抗体货号: 30796别名: PP4; ANX5; ENX2; RPRGL3; HEL-S-7应用: WB,IF,FCM反应种属: Human,Mouse
-
分类: 科研抗体货号: 30805别名: PDK1; PDPK2; PDPK2P; PRO0461应用: WB,IHC,IF,FCM反应种属: Human,Mouse,Monkey,Rat
-
分类: 科研抗体货号: 30811别名: HER4; ALS19; p180erbB4应用: IF,FCM反应种属: Human

鄂公网安备42018502007531号
鄂公网安备42018502007531号

